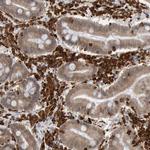
SHP-1 Antibody in Immunohistochemistry (Paraffin) (IHC (P))

Search
Invitrogen
SHP-1 Polyclonal Antibody
{{$productOrderCtrl.translations['antibody.pdp.commerceCard.promotion.promotions']}}
{{$productOrderCtrl.translations['antibody.pdp.commerceCard.promotion.viewpromo']}}
{{$productOrderCtrl.translations['antibody.pdp.commerceCard.promotion.promocode']}}: {{promo.promoCode}} {{promo.promoTitle}} {{promo.promoDescription}}. {{$productOrderCtrl.translations['antibody.pdp.commerceCard.promotion.learnmore']}}
产品信息
PA5-81944
种属反应
宿主/亚型
分类
类型
抗原
偶联物
形式
浓度
规格
纯化类型
保存液
内含物
保存条件
运输条件
RRID
产品详细信息
Immunogen sequence: HAGPIIVHCS AGIGRTGTII VIDMLMENIS TKGLDCDIDI QKTIQMVRAQ RSGMVQTEAQ YKFIYVAIAQ FIETTKKKLE VLQSQKGQES EYGNITYPPA MKNAHAKASR TSSKHKEDVY ENLHTKNKRE EKVKKQRSAD KEKSKGSLK
Highest antigen sequence indentity to the following orthologs: Rat - 91%, Mouse - 92%.
靶标信息
SHP-1 (PTPN6) is a non-receptor protein tyrosine phosphatase that is expressed primarily in hematopoietic cells. The enzyme is composed of two SH2 domains, a tyrosine phosphatase catalytic domain, and a carboxy-terminal regulatory domain. SHP-1 removes phosphates from target proteins to downregulate several tyrosine kinase-regulated pathways. In hematopoietic cells, the amino-terminal SH2 domain of SHP-1 binds to tyrosine phosphorylated erythropoietin receptors (EpoR) to negatively regulate hematopoietic growth. Overexpression of SHP-1 in epithelial cells results in dephosphorylation of the Ros receptor tyrosine kinase and subsequent downregulation of Ros-dependent cell proliferation and transformation. Following ligand binding in myeloid cells, SHP-1 associates with the IL-3R beta chain and downregulates IL-3-induced tyrosine phosphorylation and cell proliferation.
仅用于科研。不用于诊断过程。未经明确授权不得转售。
篇参考文献 (0)
生物信息学
蛋白别名: EC 3.1.3.48; hematopoietic cell phosphatase; Hematopoietic cell protein-tyrosine phosphatase; Protein-tyrosine phosphatase 1C; Protein-tyrosine phosphatase SHP-1; PTN6; PTP-1C; SH-PTP1; SH2 phosphatase 1; Tyrosine-protein phosphatase non-receptor type 6; unnamed protein product
基因别名: HCP; HCPH; HPTP1C; PTP-1C; PTP1C; Ptph6; PTPN6; SH-PTP1; SHP-1; SHP-1L; SHP1
UniProt ID: (Human) P29350, (Rat) P81718
Entrez Gene ID: (Human) 5777, (Rat) 116689